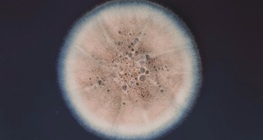
Penicillin

Renesansa u Europi smatra se mostom koji povezuje srednji vijek i suvremenu povijest.
Firenca je glavni grad talijanske regije Toskane, a ujedno i grad s najvećom naseljenošću.
Rukomet je popularan sport u Europi. Posljednjih nekoliko desetljeća javlja se i kao olimpijska disciplina.
Na području Nacionalnog parka Fiordland nalazi se najljepša prirodna atrakcija Novog Zelanda: Milford Sound.
Ogromna otvorena područja savanskih travnjaka nalaze se u tropskoj Africi. Dom su ogromnom broju raznolikih životinjskih vrsta.
Lemuri su vrsta primata koji žive na otoku Madagaskar. Iz našeg ćete filma saznati mnogo zanimljivih stvari o njima.
Većina ljudi je vjerojatno upoznata s raznim oblicima javnog prijevoza, kao što su autobusi, tramvaji i podzemna željeznica. Međutim, na Zemlji postoje mjesta gdje bi uporaba tradicionalnih oblika prijevoza bila neizvediva.
Nepolarne tvari se otapaju u nepolarnim otapalima, dok se polarne tvari otapaju u polarnim otapalima.
Rastavljanje mješavina u slučaju topivosti jedne tvari u vodi.
Film koji prikazuje život tri čovjekolika majmuna koji žive u Africi: čimpanze, bonobo i gorile.
Pomoću limenke, vode i Bunsenovog plamenika možemo napraviti posebnu parnu turbinu.
The two toxic substances combine in a highly exothermic reaction to form table salt.
Penicillin is the most widely recognised antibiotic. Antibiotics kill or inhibit the growth and synthesis of bacteria. Penicillin is produced as a metabolite of a certain species of Penicillium mould which is grown on an agar-agar substance.
Industrijska prerada svinjskog mesa uvelike se razlikuje od svinjokolje kod kuće. Filmić prikazuje čitav proces proizvodnje.
Bjelančevine su osjetljive na promjene okoliša. U ovom filmu prikazat ćemo koliko je jednostavno promijeniti njihovu molekularnu strukturu.
Nemoj pušiti! Ovaj film prikazuje nam što se događa u plućima pušaća tijekom pušenja.
Prirodni plin i nafta u današnje vrijeme jedni su od najvažnijih izvora energije i sirovina.
Što je veći protok i brzina vode rijeke, to je jača njezina sila oblikovanja površine.
The pulse is the rhythmic expansion of the arteries caused by the outflow of blood from the heart when it contracts.